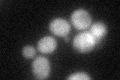
YBR212W
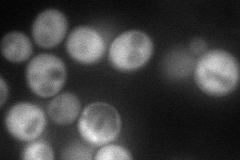
YBR212W
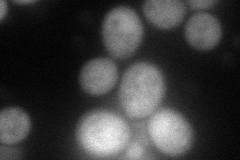
YBR212W
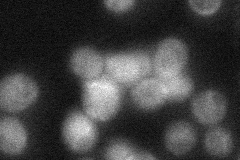
YBR212W
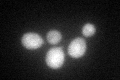
YBR212W
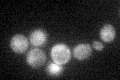
YBR212W

View description
RNA binding protein that negatively regulates growth rate; interacts with the 3' UTR of the mitochondrial porin (POR1) mRNA and enhances its degradation; overexpression impairs mitochondrial function; expressed in stationary phase
Localization:
Intensity:
Fold change:
Significance:
-
C’ GFP library in SD
cytosol43.9 -
N' NOP1pr-GFP in SD
cytosol108.788 -
N' TEF2pr-mCherry in SD
cytosol74.0602 -
N' NATIVEpr-GFP in SD
cytosol,punctate35.2634 -
N' TEF2pr-VC and Cyto-VN in SD

#N/A0 -
C’ GFP library in SD+DTT
cytosol45.491.03No -
C’ GFP library in SD+H2O2

cytosol53.81.22No -
C’ GFP library in Starvation Media
cytosol39.460.89No -
C’ GFP library on the background of Pup2-DaMP

N/A -
C’ GFP library on the background of CCT mutant

N/A0N/AYes
